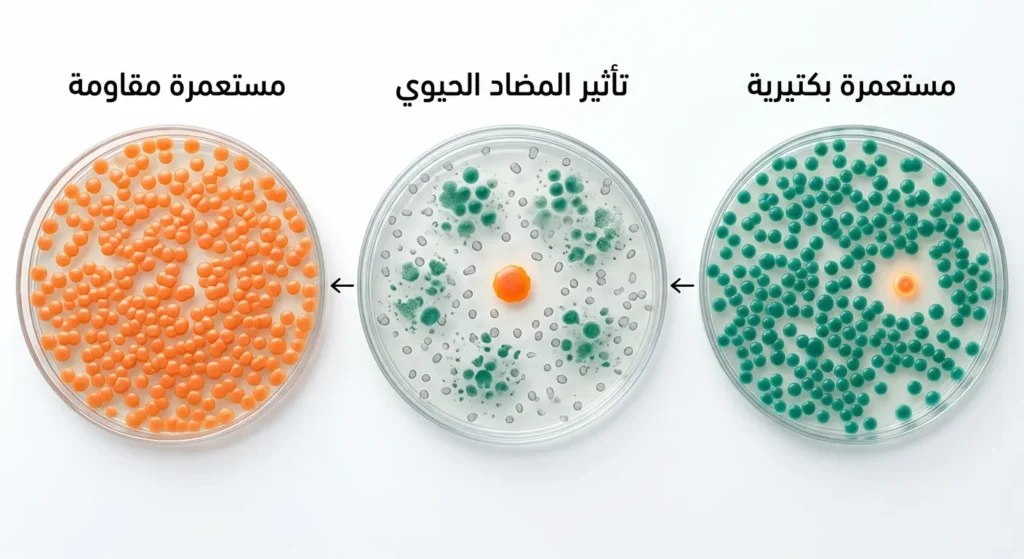
تسلسل بصري واقعي يُظهر مراحل تطوّر مقاومة البكتيريا للمضادات الحيوية من خلال بقاء الأقوى وتكاثره

المضادات الحيوية: الأنواع، الاستخدامات، والأضرار الخفية
المضادات الحيوية (Antibiotics) مواد كيميائية ذات أصل طبيعي أو اصطناعي، تعمل على قتل البكتيريا (Bacteria) أو تثبيط نموها داخل الجسم. لا تؤثر على الفيروسات (Viruses) بأي صورة. تُصنَّف ضمن مجموعة العوامل المضادة للميكروبات (Antimicrobial Agents)، وتُعَدُّ من أكثر الأدوية تأثيراً في تاريخ الطب الحديث.
هل سبق أن وصف لك الطبيب مضاداً حيوياً، فأخذت نصف الجرعات لأنك شعرت بالتحسن مبكراً؟ أو ربما طلبت من الصيدلاني أن يعطيك “شيئاً قوياً” لنزلة البرد، فأعطاك أموكسيسيلين دون وصفة؟ أنت لست الوحيد الذي فعل ذلك، فهذا السلوك شائع جداً في العالم العربي عموماً وفي المملكة العربية السعودية خصوصاً. لكن هذه الأفعال البسيطة تُشكّل خطراً تراكمياً لا تراه بعينيك، وستجد في هذا المقال ما يجعلك تعيد النظر في كل ما تعرفه عن هذه الأدوية.
- المضادات الحيوية تقتل البكتيريا فقط — ولا تؤثر على الفيروسات إطلاقاً.
- كل عائلة من المضادات الحيوية تعمل بآلية جزيئية مختلفة داخل الخلية البكتيرية.
- مفعولها السريري يبدأ يظهر بعد 48 – 72 ساعة من بدء العلاج — لا بعد ساعات.
- لا تستخدمها لنزلات البرد أو الإنفلونزا أو كوفيد-19 — إنها حالات فيروسية لا تستجيب لها.
- لا تُوقف الكورس مبكراً — حتى لو شعرت بالتحسن في اليوم الثالث.
- لا تشترِها من الصيدلية دون وصفة طبية — في السعودية هذا مخالف للنظام منذ 2017.
- الحليب يُبطل مفعول التتراسيكلينات — افصل بينهما بـ 2 ساعة على الأقل.
- 1.27 مليون وفاة سنوياً تُعزى مباشرةً لعدوى بكتيرية مقاومة — وفق تقرير WHO 2024.
- قد يرتفع الرقم إلى 10 ملايين وفاة سنوياً بحلول 2050 بدون تدخل حازم.
- 48% من المضادات الحيوية في السعودية تُصرَف بدون وصفة طبية وفق دراسة 2020.
- تناول البروبيوتيك (Probiotics) خلال الكورس العلاجي — لا بعده فحسب.
- اشرب لترين من الماء يومياً طوال فترة العلاج لمساعدة الكليتين على إفراز الدواء.
- أخبر طبيبك بجميع أدويتك المزمنة — التداخل الدوائي قد يكون صامتاً لكنه خطير.
- للفئات الخاصة (الحوامل، الأطفال، كبار السن): استشر طبيبك قبل أي مضاد حيوي دون استثناء.
📌 مثال من الواقع — قرار يوميّ قد يُغيّر حياتك
تخيّل أم في الرياض، طفلها يعاني من التهاب في الحلق منذ يومين، وحرارته 38.5 درجة. توجّهت إلى الصيدلية وطلبت “مضاداً حيوياً قوياً”. أعطاها الصيدلاني أزيثروميسين (Azithromycin) بدون وصفة. بعد يومين تحسّن الطفل. قالت الأم: “الحمد لله، الدواء نفع.” لكن الحقيقة هي أن 70-80% من التهابات الحلق عند الأطفال فيروسية وتزول وحدها خلال 7 أيام. ما حدث هو أن الطفل شُفي رغم الدواء لا بسببه، لكن البكتيريا في جسمه تعرّضت لجرعة غير ضرورية، مما يُهيّء لتطوّر مقاومة مستقبلية. هذا السيناريو يتكرر آلاف المرات يومياً في المملكة، وفق ما رصدته وزارة الصحة السعودية ضمن برامج مكافحة مقاومة المضادات الحيوية.
ما هي المضادات الحيوية وكيف تعمل؟
الاكتشاف الذي غيّر تاريخ الإنسانية
في عام 1928، لاحظ الطبيب البريطاني ألكسندر فلمينج (Alexander Fleming) في مختبره شيئاً غريباً؛ إذ اكتشف أن فطراً من نوع بنيسيليوم كريسوجينوم (Penicillium chrysogenum) أتلف مستعمرات بكتيرية في طبق زرع. كان ذلك بداية عصر جديد. لقد خلص في البداية إلى أن هذا الفطر يُفرز مادة تقتل البكتيريا، وأسماها البنسلين (Penicillin). لم يُدرك فلمينج آنذاك أن اكتشافه سيُنقذ ما يزيد على 200 مليون حياة بشرية خلال القرن الماضي. ثم جاء هوارد فلوري وإرنست تشين عام 1940 لتطوير البنسلين دواءً صالحاً للاستخدام السريري.
آلية العمل — كيف تقتل البكتيريا؟

المضادات الحيوية لا تعمل جميعها بطريقة واحدة؛ فلكل عائلة آليتها المميزة على المستوى الجزيئي. بعضها يهاجم جدار الخلية البكتيرية (Cell Wall)، كالبنسلينات والسيفالوسبورينات؛ إذ تُثبّط إنزيم ترانسببتيداز (Transpeptidase) المسؤول عن ربط ببتيدوغليكان (Peptidoglycan) جدار الخلية، مما يُضعفه حتى ينفجر. وبعضها يستهدف غشاء الخلية البكتيرية مباشرة كالبوليميكسينات (Polymyxins). وبعضها يُعطّل تخليق البروتين البكتيري (Protein Synthesis) عبر الارتباط بوحدات الريبوسوم (Ribosomes) كالتتراسيكلينات والماكروليدات.
خلايا الإنسان تختلف جوهرياً عن الخلايا البكتيرية؛ إذ تفتقر إلى جدار الخلية البكتيري، ولها ريبوسومات مختلفة (80S مقابل 70S عند البكتيريا). لهذا السبب بالتحديد، يستطيع المضاد الحيوي أن يُميّز بين ما يجب مهاجمته وما يجب تجنّبه.
💡 معلومة سريعة
يوجد في جسم الإنسان البالغ ما يزيد على 38 تريليون خلية بكتيرية، وهو عدد يفوق خلايا الجسم نفسه. المضادات الحيوية لا تُميّز دائماً بين البكتيريا الضارة والنافعة، مما يجعل تأثيرها على الميكروبيوم (Microbiome) نقطةً مثيرة للجدل العلمي حتى عام 2026.
لماذا لا تعالج المضادات الحيوية الإنفلونزا ونزلات البرد؟

هذا السؤال يبدو بسيطاً، لكن إجابته تُفسّر لك سبب أزمة مقاومة المضادات الحيوية العالمية.
الفيروسات (Viruses) كائنات مختلفة تماماً عن البكتيريا؛ فهي ليست خلايا حية بالمعنى الكامل، بل هي جُزَيئات جينية مغلّفة لا تمتلك جداراً خلوياً ولا ريبوسومات ولا عمليات استقلابية مستقلة. إنها تعيش داخل خلاياك أنت، وتستخدم آلياتها للتكاثر. وعليه فإن المضاد الحيوي لا يجد فيها أي هدف يضربه.
الإنفلونزا (Influenza)، ونزلات البرد (Common Cold)، وكوفيد-19 (COVID-19)، والتهاب الكبد الفيروسي (Viral Hepatitis)، كلها حالات لا جدوى من العلاج بالمضادات الحيوية. فما هو السبب إذاً في كثرة وصفها لهذه الحالات؟ الإجابة مزيج من ضغط المريض على الطبيب، وتأكيد الطبيب “لقطع الطريق” على العدوى البكتيرية الثانوية، وغياب التشخيص الدقيق. والنتيجة كارثية طويلة المدى.
أثبتت دراسة منشورة في مجلة The Lancet Infectious Diseases عام 2023 أن 57% من وصفات المضادات الحيوية في الدول متوسطة الدخل تُصرَف لحالات فيروسية لا تستفيد منها، مما يُسرّع وتيرة ظهور السلالات البكتيرية المقاومة.
| وجه المقارنة | 🦠 البكتيريا (Bacteria) | 🔴 الفيروسات (Viruses) |
|---|---|---|
| طبيعة الكائن | خلية حية كاملة ومستقلة | جزيء جيني مغلّف — غير حي باستقلالية |
| جدار الخلية | موجود ✓ (ببتيدوغليكان) | غائب ✗ |
| الريبوسومات | موجودة ✓ (70S) | غائبة ✗ (يستخدم ريبوسومات الخلية المضيفة) |
| التكاثر | مستقل — ينقسم بذاته | داخل خلايا الإنسان حصراً — يختطف آلياتها |
| العمليات الأيضية | موجودة ✓ (إنزيمات، طاقة، استقلاب) | غائبة ✗ — لا يمتلك استقلاباً مستقلاً |
| هل يعمل عليه المضاد الحيوي؟ | نعم ✓ — يقتلها أو يوقف نموها | لا ✗ — لا يوجد هدف قابل للاستهداف |
| العلاج المناسب | المضادات الحيوية (Antibiotics) | مضادات الفيروسات (Antivirals) أو العلاج الداعم |
| أمثلة على الأمراض | التهاب اللوزتين البكتيري، التهاب المسالك البولية، السل | الإنفلونزا، نزلات البرد، كوفيد-19، الهربس |
| التشخيص التفريقي | ثقافة بكتيرية (Culture)، CRP، CBC | PCR، اختبارات الأجسام المضادة، CBC |
| خطر مقاومة الأدوية | مرتفع جداً عند الاستخدام غير الصحيح | مقاومة مضادات الفيروسات موجودة لكن أقل شيوعاً |
اقرأ أيضاً:
- مضادات الهيستامين — كيف تعمل وما الفرق بين أجيالها؟
- مضادات الاحتقان: الأنواع، الاستخدام الآمن، والأضرار الخفية
ما هي أنواع وعائلات المضادات الحيوية؟
البنسلينات (Penicillins)
تُعَدُّ البنسلينات أول وأقدم عائلة من المضادات الحيوية. تشمل أموكسيسيلين (Amoxicillin)، وأمبيسيلين (Ampicillin)، وبيبيراسيلين-تازوباكتام (Piperacillin-Tazobactam). تعمل على تثبيط تخليق جدار الخلية البكتيرية. تُستخدم لعلاج التهابات الجهاز التنفسي والأذن والجيوب الأنفية والجلد. تبقى الخيار الأول لالتهاب اللوزتين البكتيري الناجم عن العقديات (Streptococcus). أما حساسية البنسلين (Penicillin Allergy) فتُصيب نحو 10% من المرضى، وإن كانت الدراسات الحديثة تُشير إلى أن 90% منهم لا يعانون في الواقع من حساسية حقيقية لدى الاختبار الدقيق.
السيفالوسبورينات (Cephalosporins)
تنتمي إلى “الجيل” ذاته من البنسلينات من حيث آلية العمل، لكنها أوسع طيفاً وأكثر استقراراً في مواجهة بعض إنزيمات بيتا-لاكتاماز (Beta-Lactamase) التي تُنتجها بعض البكتيريا المقاومة. تُقسَّم إلى خمسة أجيال؛ إذ يكون الجيل الأول (مثل سيفازولين – Cefazolin) أكثر فاعلية ضد البكتيريا موجبة الغرام (Gram-positive Bacteria)، بينما يمتلك الجيل الثالث (مثل سيفترياكسون – Ceftriaxone) طيفاً أوسع يشمل سالبة الغرام (Gram-negative Bacteria). يُلجأ إليها عادةً حين يثبت المضاد الحيوي من الجيل الأول عدم فاعليته.
الماكروليدات (Macrolides)
تشمل أزيثروميسين (Azithromycin)، وكلاريثروميسين (Clarithromycin)، وإريثروميسين (Erythromycin). تُثبّط تخليق البروتين عبر الارتباط بوحدة 50S من الريبوسوم البكتيري. هي الخيار البديل الأمثل للمرضى الذين يعانون من حساسية البنسلين. تتميّز بامتصاصها الجيد عند تناولها فموياً وقدرتها على اختراق الأنسجة بشكل عميق، مما يجعلها فعّالة في التهابات الرئة غير النمطية (Atypical Pneumonia) التي يُسبّبها الميكوبلازما (Mycoplasma pneumoniae).
الفلوروكينولونات (Fluoroquinolones)
تُعَدُّ من العائلات “الثقيلة” في طب المضادات الحيوية؛ وتشمل سيبروفلوكساسين (Ciprofloxacin)، وليفوفلوكساسين (Levofloxacin)، وموكسيفلوكساسين (Moxifloxacin). آليتها مختلفة؛ إذ تُعطّل إنزيمي DNA Gyrase وTopoisomerase IV المسؤولَين عن تضاعف الحمض النووي البكتيري. هي فعّالة جداً ضد البكتيريا سالبة الغرام، وتُستخدم في العدوى الشديدة كالتهاب المسالك البولية المعقّد والتهاب الرئة. غير أن وكالة الغذاء والدواء الأمريكية (FDA) أصدرت عام 2023 تحذيرات محدّثة بشأن آثارها الجانبية على الأوتار والجهاز العصبي، وأوصت بحصر استخدامها للحالات التي لا يوجد فيها بديل أكثر أماناً.
عائلات أخرى مهمة
تشمل قائمة المضادات الحيوية عائلات إضافية لا يمكن إغفالها. التتراسيكلينات (Tetracyclines) كدوكسيسيكلين (Doxycycline) تُستخدم لعلاج حبّ الشباب والملاريا وعدوى الكلاميديا. الأمينوغليكوزيدات (Aminoglycosides) كجنتاميسين (Gentamicin) تُحجز للحالات الشديدة بسبب سميّتها الكلوية والأذنية. الكاربابينيمات (Carbapenems) كإيميبينيم (Imipenem) هي “الخط الأخير” الذي يُستخدم حين تفشل كل الخيارات الأخرى. وأخيراً، الغليكوببتيدات (Glycopeptides) كفانكوميسين (Vancomycin) التي تبقى السلاح الأساسي ضد البكتيريا موجبة الغرام المقاومة.
| العائلة | أمثلة تجارية / علمية | آلية العمل | أبرز الاستخدامات | تحذيرات جوهرية |
|---|---|---|---|---|
| البنسلينات (Penicillins) |
أموكسيسيلين، أمبيسيلين، بيبيراسيلين-تازوباكتام |
تثبيط تخليق جدار الخلية البكتيرية (PBPs) | التهاب اللوزتين، الأذن، الجيوب، الجهاز التنفسي | حساسية البنسلين (~10% من المرضى)؛ تحقق دائماً قبل الوصف |
| السيفالوسبورينات (Cephalosporins) |
سيفازولين (جيل 1)، سيفترياكسون (جيل 3) |
تثبيط PBPs — طيف أوسع من البنسلينات | العدوى الشديدة، التهاب السحايا، عدوى ما بعد الجراحة | تفاعل تقاطعي محتمل مع حساسية البنسلين (~1-2%) |
| الماكروليدات (Macrolides) |
أزيثروميسين، كلاريثروميسين، إريثروميسين | تثبيط الريبوسوم 50S → وقف تخليق البروتين | بديل حساسية البنسلين، الالتهاب الرئوي غير النمطي، الكلاميديا | قد يُطيل فترة QT في القلب؛ احذر مع أدوية القلب |
| الفلوروكينولونات (Fluoroquinolones) |
سيبروفلوكساسين، ليفوفلوكساسين، موكسيفلوكساسين | تثبيط DNA Gyrase وTopoisomerase IV | التهاب المسالك البولية المعقد، العدوى الشديدة بالبكتيريا سالبة الغرام | خطر التهاب الأوتار وتمزّقها؛ خطر تشريح الأبهر (تحذير FDA 2023) |
| التتراسيكلينات (Tetracyclines) |
دوكسيسيكلين، مينوسيكلين | تثبيط الريبوسوم 30S → وقف تخليق البروتين | حب الشباب، الملاريا، الكلاميديا، داء لايم | ممنوع تحت سن 8 سنوات وخلال الحمل (تلوين الأسنان الدائم) |
| الأمينوغليكوزيدات (Aminoglycosides) |
جنتاميسين، أميكاسين، توبراميسين | تثبيط الريبوسوم 30S بشكل لا عكسي | العدوى الشديدة سالبة الغرام، الإنتان (Sepsis) | سُمية كلوية وأذنية — تستلزم مراقبة مستوى الدواء في الدم |
| الكاربابينيمات (Carbapenems) |
إيميبينيم، ميروبينيم، إرتابينيم | تثبيط PBPs — طيف واسع جداً يشمل البيتا-لاكتاماز | “الخط الأخير” للعدوى المقاومة متعددة الأدوية | الاستخدام المحدود ضروري لحماية فاعليتها من المقاومة |
| الغليكوببتيدات (Glycopeptides) |
فانكوميسين، تيكوبلانين | تثبيط تخليق جدار الخلية عبر ارتباط مختلف عن البيتا-لاكتام | MRSA، التهاب الشغاف، عدوى المستشفيات بالبكتيريا موجبة الغرام | سُمية كلوية؛ يستلزم رصد مستوياته في الدم بانتظام |
🔬 لحظة علمية
علم الصيدلة الجينية (Pharmacogenomics) بدأ يُغيّر طريقة وصف المضادات الحيوية. اعتباراً من 2025، تتجه بعض المستشفيات الأوروبية إلى اختبار الجينوم البكتيري الكامل خلال ساعات، لاختيار المضاد الحيوي الأكثر دقة وتجنّب المقاومة.
اقرأ أيضاً: مضادات الالتهاب: أنواعها، استخداماتها، والآثار الجانبية
المختبر الفسيولوجي — للمهتمين بالتفاصيل العلمية الدقيقة
تعمل المضادات الحيوية من فئة البيتا-لاكتام (β-Lactams) عبر ارتباطها التنافسي بالبروتينات الرابطة للبنسلين (Penicillin-Binding Proteins – PBPs)؛ وهي إنزيمات كاربوكسيببتيداز وترانسببتيداز تقع على السطح الداخلي لغشاء الخلية البكتيرية، وتتولى إتمام التشابك الشبكي (Cross-linking) لخيوط الببتيدوغليكان.
يُفضي تثبيط هذه الإنزيمات إلى انهيار بنيوي في جدار الخلية يُحوّل الضغط الأسموزي (Osmotic Pressure) الداخلي إلى قوة تدميرية تُمزّق غشاء البلازما. في المقابل، تُؤثّر عائلة الأمينوغليكوزيدات على المرحلة التكوينية للبروتين بالارتباط بالموضع 30S من الريبوسوم، ما يُشوّه قراءة mRNA ويُنتج سلاسل ببتيدية غير وظيفية تُراكم سمية داخل الخلية حتى موتها.
الخطر الصامت — ما هو شبح مقاومة المضادات الحيوية (Antibiotic Resistance)؟
تحذير منظمة الصحة العالمية الذي يجب ألا تتجاهله
🚨 صندوق اقتباس طبي — تصريح منظمة الصحة العالمية (WHO)
صنّفت منظمة الصحة العالمية (WHO) في تقريرها الصادر عام 2024 مقاومة مضادات الميكروبات (Antimicrobial Resistance – AMR) باعتبارها واحدة من أكبر التهديدات الصحية العالمية. وتُقدِّر المنظمة أن 1.27 مليون وفاة سنوية تُعزى مباشرة إلى عدوى بكتيرية مقاومة للأدوية، وقد يرتفع هذا الرقم إلى 10 ملايين وفاة سنوية بحلول عام 2050 إذا لم تُتّخذ إجراءات صارمة.
المصدر: منظمة الصحة العالمية — تقرير مقاومة مضادات الميكروبات 2024
كيف تُطوّر البكتيريا مقاومتها؟
البكتيريا لا تموت جميعها بالجرعة الأولى من المضاد الحيوي. بعضها يحمل طفرات جينية عشوائية تمنحه قدرة على الصمود. حين يموت الضعيف ويبقى القوي، يتكاثر هذا الأخير ويورث مقاومته. كما تتبادل البكتيريا المقاومة جيناتها عبر آلية تُسمى النقل الأفقي للجينات (Horizontal Gene Transfer)، مما يُسرّع انتشار المقاومة بصورة لا يمكن التنبؤ بها.
أثبتت دراسة منشورة في مجلة Nature Medicine عام 2022 أن الاستخدام المفرط للمضادات الحيوية في تربية الدواجن والماشية يُساهم في نقل جينات المقاومة إلى البكتيريا البشرية عبر السلسلة الغذائية، مما يُنبّه إلى أن المشكلة لا تقتصر على الاستخدام البشري وحده.
5 خطوات عملية يمكن للمريض القيام بها لمنع هذه الكارثة
- لا تطلب مضاداً حيوياً لنزلات البرد أو الإنفلونزا مهما اشتدّت الأعراض.
- أكمل الجرعة الكاملة التي وصفها الطبيب، حتى لو تحسّنت في اليوم الثالث.
- لا تستخدم بقايا مضادات حيوية من وصفة قديمة لعلاج أعراض جديدة.
- تجنّب شراء المضادات الحيوية من الصيدلية دون وصفة طبية.
- أبلغ طبيبك دائماً عن أي حساسية سابقة لمضادات حيوية معيّنة.
🌡️ حقيقة لا تُصدَّق
في عام 2019، كُشف في المملكة العربية السعودية أن نحو 48% من المضادات الحيوية تُصرَف دون وصفة طبية، وفق دراسة نشرتها مجلة Antibiotics عام 2020. أعلنت وزارة الصحة السعودية منذ عام 2017 إلزامية الوصفة الطبية لصرف المضادات الحيوية، لكن التطبيق لا يزال يواجه تحديات ميدانية.
اقرأ أيضاً: الفحوصات الطبية الدورية: متى يجب أن تبدأ وما الذي تحتاجه في كل عمر؟
ما هي الآثار الجانبية والمخاطر المخفية للمضادات الحيوية؟
الآثار الشائعة التي تعرفها لكنك تتجاهلها
اضطرابات الجهاز الهضمي هي أكثر الآثار الجانبية للمضادات الحيوية شيوعاً؛ إذ تشمل الغثيان، والإسهال، وآلام البطن. هذه الاضطرابات ليست مجرد “إزعاج”؛ بل هي انعكاس لتدمير المضاد الحيوي للبكتيريا النافعة في الأمعاء. كما قد يُسبّب الأموكسيسيلين طفحاً جلدياً في بعض المرضى، فيما قد يتسبّب الدوكسيسيكلين في حساسية مفرطة للضوء (Photosensitivity).
من ناحية أخرى، قد يؤدي استخدام المضادات الحيوية إلى تعزيز نمو الفطريات كالكانديدا (Candida albicans) في الفم والمهبل، نتيجة القضاء على البكتيريا المنافسة لها.
الآثار الجانبية الخطيرة — متى تتجه إلى الطوارئ؟

تبقى صدمة الحساسية (Anaphylaxis) أشد الآثار الجانبية خطورة وأسرعها تطوراً. تظهر خلال دقائق من تناول الدواء أو حقنه، وتتجلّى في انخفاض مفاجئ في ضغط الدم، وضيق شديد في التنفس، وتورّم الوجه والحلق. هذه حالة طارئة تستوجب الذهاب إلى الطوارئ فوراً دون تأخير.
بالإضافة إلى ذلك، ارتبطت الفلوروكينولونات بالتهاب الأوتار وتمزّقها (Tendinitis/Tendon Rupture)، خاصةً وتر أخيل (Achilles Tendon). وقد أثبتت دراسة منشورة في JAMA Internal Medicine عام 2021 ارتباط الفلوروكينولونات بارتفاع خطر تشريح الأبهر (Aortic Dissection) وتمدده، مما أفضى إلى تحديث تحذيرات الـ FDA في عام 2023. فضلاً عن ذلك، يُمثّل التهاب القولون الغشائي الكاذب (Pseudomembranous Colitis) الناجم عن بكتيريا كلوستريديوم ديفيسيل (Clostridioides difficile) خطراً جسيماً، خاصةً لدى المرضى المسنّين الذين يتلقون جرعات طويلة الأمد.
اقرأ أيضاً: الدليل الطبي الشامل لارتفاع ضغط الدم: الأسباب، الأعراض، وطرق العلاج الفعالة
الوصفة الطبية من موقعنا
هذه هي أبرز التوصيات التي يُقدّمها موقع وصفة طبية لكل من يتناول دورة علاجية بالمضادات الحيوية:
- توقيت الجرعة مع الوجبات أو بدونها: البنسلينات والتتراسيكلينات يتأثّر امتصاصها بالطعام؛ لذا اتبع تعليمات الطبيب بدقة؛ فالجرعة في الوقت الخطأ تعني نصف المفعول.
- البروبيوتيك بالتزامن مع العلاج: تناول مكملات البروبيوتيك (Probiotics) كالـ Lactobacillus rhamnosus يحافظ على بكتيريا القناة الهضمية النافعة التي يُدمّرها المضاد الحيوي، مما يُقلّل الإسهال المرتبط بالعلاج بنسبة تصل إلى 42% وفق تحليل تلوي في Cochrane Library.
- شرب الماء بكميات كافية: الترطيب الجيد يُساعد الكليتين على التخلّص من بقايا الدواء وتجنّب الكريستالات التي قد تتشكّل في الحالب عند استخدام بعض الأصناف كسلفاميثوكسازول (Sulfamethoxazole).
- عدم مضاعفة الجرعة إن نسيت: تناول الجرعة الفائتة حين تتذكّرها إن كان الوقت بعيداً عن الجرعة التالية، ولا تضاعف الجرعة أبداً؛ لأن التركيز الزائد قد يُسبّب سمية كلوية أو كبدية.
- المتابعة مع الطبيب إن لم تتحسّن خلال 48-72 ساعة: عدم التحسّن يعني احتمالَين: إما خطأ في التشخيص وإما مقاومة بكتيرية، وكلاهما يحتاج مراجعة طبية.
- إكمال الكورس العلاجي الكامل دون استثناء: إيقاف الدواء مبكراً يترك البكتيريا الأقوى حيّة، وهي ستعاود الهجوم بشكل أشد وأصعب علاجاً.
- تجنّب الكحول خلال فترة العلاج: الكحول يُقلّل فاعلية بعض المضادات الحيوية ويُفاقم أعراض الجهاز الهضمي، وقد يُسبّب تفاعلاً حاداً مع مترونيدازول (Metronidazole).
ما هي التداخلات الدوائية والغذائية الأهم للمريض؟
أطعمة ومشروبات تُبطل مفعول المضاد الحيوي

كثيرون لا يعلمون أن كوب الحليب أو منتجات الألبان يستطيع أن يُبطّل مفعول التتراسيكلينات والكينولونات. آلية ذلك تكيميائية بحتة؛ إذ يرتبط الكالسيوم الموجود في الحليب بجزيئات الدواء مُشكّلاً مُعقّداً غير قابل للامتصاص في الأمعاء. على النقيض من ذلك، يُحسّن عصير البرتقال امتصاص أموكسيسيلين عند بعض المرضى. أما عصير الغريب فروت (Grapefruit Juice) فهو مشكلة مع طيف واسع من الأدوية عبر تثبيطه لإنزيم CYP3A4 الكبدي.
بالمقابل، تُوصي الأدلة السريرية بالفصل بين تناول الحليب والتتراسيكلين بساعتين على الأقل.
تداخلات دوائية لا يُستهان بها
الوارفارين (Warfarin) ومضادات التخثّر يرتفع مفعولها بشكل خطير حين تُجمع مع بعض المضادات الحيوية كالسيبروفلوكساسين وميترونيدازول؛ مما قد يُفضي إلى نزيف داخلي. حبوب منع الحمل قد يتراجع مفعولها مع الريفامبيسين (Rifampicin) بسبب تسريع إنزيمات الكبد. والميترونيدازول مع الكحول يُحدث تفاعل أنتابوس (Antabuse Reaction) المميّز بالاحمرار الشديد والغثيان.
⚠️ تنبيه دوائي
إذا كنت تتناول أدوية مُزمنة كمضادات التخثّر أو أدوية الصرع أو الأدوية النفسية، فأخبر طبيبك بها جميعاً قبل أي وصفة لمضاد حيوي. التداخل الدوائي قد لا يظهر فوراً، لكنه يُتراكم بصمت.
اقرأ أيضاً:
- مرض السكري: ما هو وكيف تتعرف على أعراضه وأسبابه؟
- مكملات أوميغا 3: الفوائد المؤكدة، الجرعات الصحيحة، وكيف تتجنب الخداع التجاري
هل المضادات الحيوية آمنة للحوامل والأطفال وكبار السن؟
الحوامل والمرضعات — خريطة الأمان والخطر
يقلق كثيرون حول هذا الموضوع، وهذا قلق مشروع. الأموكسيسيلين والأمبيسيلين يُصنَّفان من الأكثر أماناً للحامل (فئة B حسب التصنيف القديم للـ FDA). في المقابل، التتراسيكلينات ممنوعة منعاً باتاً خلال الثلثين الثاني والثالث من الحمل؛ إذ تترسّب في عظام وأسنان الجنين وتُسبّب تلوّناً دائماً. الكلوراملفنيكول (Chloramphenicol) ممنوع في الثلث الثالث بسبب “متلازمة الطفل الرمادي” (Gray Baby Syndrome). الكينولونات تُتجنَّب لتأثيرها المحتمل على غضاريف الجنين.
أما في الرضاعة، فمعظم المضادات الحيوية تنتقل إلى حليب الأم بنسب متفاوتة. الميترونيدازول ينتقل بكميات تُسبّب رائحة مرّة في الحليب وقد يُزعج الرضيع، لذا يُنصح بإيقاف الرضاعة مؤقتاً أثناء أخذه.
الأطفال والرضّع — تحذيرات لا تتهاون بها
الجرعة عند الأطفال تُحسَب دائماً على وزن الجسم (mg/kg)، وليس بناءً على العمر وحده. التتراسيكلين ممنوع تماماً لمن هم دون سن 8 سنوات بسبب تأثيره الدائم على صبغة الأسنان وتخلخل العظام. كلوراملفنيكول ممنوع عند الرضّع. وأثبتت دراسة نشرتها مجلة Pediatrics عام 2020 أن التعرّض المبكر للمضادات الحيوية في الأشهر الأولى من الحياة يرتبط بزيادة خطر الإصابة بالربو والسمنة والأمراض الالتهابية المزمنة لاحقاً، عبر تأثيرها على ميكروبيوم الأمعاء الناشئ.
كبار السن وأصحاب الأمراض المزمنة (الكلى والكبد)
الكلى والكبد هما العضوان اللذان يتحمّلان أعباء تصفية الأدوية وإفرازها. يتراجع معدل الترشيح الكبيبي (Glomerular Filtration Rate – GFR) طبيعياً مع التقدّم في العمر، مما يعني تراكم الدواء في الجسم عند تناول الجرعات المعتادة. وعليه فإن الأمينوغليكوزيدات تستلزم رصد مستوياتها في الدم بانتظام عند المسنّين، وكذلك الكينولونات. المرضى الذين يتناولون أدوية تحسين وظائف الكلى يحتاجون مراجعة تفصيلية للجرعة مع طبيبهم.
🩺 رأي طبيب متخصص — من هيئة التحرير الطبية في وصفة طبية
يقول المستشار الدوائي جاسم محمد مراد، خبير الصحة والإمداد الطبي في موقع وصفة طبية:
“أنصح جميع المرضى، وبخاصة الآباء والأمهات، بعدم إعطاء أطفالهم أي مضاد حيوي تبقّى من كورس علاجي سابق، حتى لو بدت الأعراض مشابهة. فالبكتيريا المسبّبة قد تكون مختلفة تماماً، والجرعة المتبقية غير كافية لإتمام العلاج، مما يُفضي إلى فشل علاجي وتعزيز مقاومة بكتيرية فردية وجماعية. الوصفة الطبية الجديدة لكل عدوى جديدة هي القاعدة الذهبية التي لا استثناء فيها.”
اقرأ أيضاً:
- السكري من النوع الأول: ما هو وكيف تتعامل معه منذ التشخيص حتى التعايش؟
- السكري من النوع الثاني: الدليل الشامل لفهم المرض، السيطرة عليه، وتجنب مضاعفاته
ما الذي يجب أن تعرفه عن التغذية والمضادات الحيوية؟
جرت مراجعة هذه الفقرة من قِبَل اختصاصية التغذية العلاجية الدكتورة علا الأحمد.
التغذية خلال دورة المضادات الحيوية ليست مسألة ثانوية. الأطعمة الغنية بالألياف كالخضراوات والبقوليات تُغذّي البكتيريا النافعة في الأمعاء وتُسرّع استعادة التوازن الميكروبي بعد انتهاء العلاج. الأطعمة المخمّرة كالزبادي الحيّ، والكيفر (Kefir)، والكيمتشي (Kimchi) تُزوّد الأمعاء بسلالات بكتيرية حيّة. كما يُنصح بتقليل السكريات المكرّرة خلال فترة العلاج؛ إذ تُغذّي السكريات الفطرياتِ كالكانديدا التي تنتهز غياب البكتيريا المنافسة.
من جهة ثانية، التوت البريّ (Cranberry) يُعزّز صحة المسالك البولية ولا يتداخل مع معظم المضادات الحيوية، بل يُستخدم مساعداً في علاج التهاباتها. وبالإضافة إلى ذلك، يُنصح بشرب ما لا يقل عن 2 لتر من الماء يومياً لتحسين امتصاص الدواء وتسهيل إفرازه.
🥗 نصيحة غذائية طازجة
وفق تحليل منشور في مجلة Nutrients عام 2022، فإن تناول البروبيوتيك خلال دورة المضادات الحيوية وليس بعدها فحسب، يُقلّل احتمالية الإسهال المرتبط بالمضادات الحيوية (Antibiotic-Associated Diarrhea) بنسبة تصل إلى 51%.
اقرأ أيضاً: لماذا تشعر بالتعب المستمر رغم النوم الكافي؟ الأسباب المخفية والحلول الفعالة
متى يبدأ مفعول المضاد الحيوي في الجسم؟
يُطرح هذا السؤال كثيراً في الصيدليات ومراكز الرعاية الصحية. الإجابة تختلف حسب نوع المضاد الحيوي ومسار تناوله. المضاد الحيوي الفموي (Oral) يحتاج إلى امتصاص من الأمعاء ليدخل إلى الدم، وهذا يستغرق عادةً 30 دقيقة إلى ساعتين. وصول الدواء إلى موقع العدوى بتركيز فعّال يستلزم عادةً 1 إلى 4 ساعات. لكن التحسّن السريري الملموس لا يبدأ في معظم الحالات إلا بعد 48 إلى 72 ساعة من بدء العلاج.
هذا ما يُفسّر لماذا يُخطئ كثيرون بإيقاف العلاج بعد يوم أو يومين لأنهم “لم يشعروا بفرق”؛ إذاً، الصبر ضرورة علاجية وليس مجرد توصية.
نصائح ذهبية لاستخدام آمن وفعّال من موقع وصفة طبية
أهمية الالتزام بالجرعة والمدة الزمنية
إكمال الكورس العلاجي الكامل هو القاعدة التي لا يُتهاون بها. حين يشعر المريض بالتحسّن في اليوم الثالث ويوقف الدواء، يتظنّ أنه شفي. لكن الحقيقة أن البكتيريا الأقوى والأكثر مقاومةً لا تزال على قيد الحياة. إذاً، الجرعة الناقصة لا تعني أمناً بل تعني خطراً مضاعفاً.
كيفية استعادة البكتيريا النافعة — البروبيوتيك (Probiotics) بعد الكورس

استعادة الميكروبيوم (Gut Microbiome) بعد كورس المضادات الحيوية ليست عملية تلقائية سريعة. بعض الدراسات تُشير إلى أن الميكروبيوم قد يحتاج شهراً أو أكثر لاستعادة توازنه الكامل بعد كورس واحد فقط. وتشمل خطوات المساعدة: تناول مكملات البروبيوتيك بعد انتهاء الكورس بيومين، والإكثار من الأطعمة البريبيوتيكية (Prebiotic Foods) كالثوم والبصل والموز التي تُغذّي البكتيريا النافعة.
💡 من الواقع العربي
في السعودية، يُعدّ شهر رمضان موسماً يرتفع فيه الاستهلاك الخاطئ للمضادات الحيوية، إذ يميل بعضهم لتناول جرعات مضاعفة في السحور تعويضاً عن إفطار واحد. هذا السلوك يُسبّب آثاراً جانبية حادة ويُخلّ بمستويات الدواء في الدم.
اقرأ أيضاً:
- الدليل الطبي الشامل لآلام الرأس: اكتشف أسباب الصداع، أنواعه، وطرق العلاج الفعالة
- صداع الجيوب الأنفية: أسبابه الحقيقية وعلاجه.. هل تعاني منه فعلاً؟
الخاتمة
المضادات الحيوية واحدة من أعظم انتصارات الطب الحديث. لقد أنقذت بشرية كاملة من أوبئة كانت تقضي على القرى والمدن في أسابيع. لكن هذا الانتصار العظيم يتعرّض اليوم لخطر صامت وجسيم: سوء الاستخدام والإفراط في التناول غير المبرّر. أزمة مقاومة المضادات الحيوية ليست قصة مستقبلية، بل تُودي بأرواح فعلية الآن، وتُهدّد فاعلية أسلحتنا الطبية الأكثر قيمة.
كل وصفة غير ضرورية، وكل كورس مُوقَف مبكراً، وكل حبّة تُعطى لطفل بدون تشخيص دقيق، هي لبنة صغيرة في جدار أزمة عالمية كبيرة. وعيك الشخصي بهذه المسألة هو جزء من الحل. شارك هذا المقال مع من تحب، لأن المعرفة الصحيحة هي أول دواء.
هل سبق أن أوقفت كورساً من المضادات الحيوية مبكراً؟ شاركنا تجربتك في التعليقات، فقد تُساعد شخصاً آخر على اتخاذ قرار أفضل.
المعلومات الواردة في هذه المقالة على موقع وصفة طبية هي للأغراض التوعوية والتثقيفية العامة فحسب، ولا تُشكّل بأي حال من الأحوال بديلاً عن الاستشارة الطبية المتخصصة أو التشخيص السريري أو الوصفة الطبية المعتمدة من قِبَل طبيب مرخّص.
لا تُقدم على تناول أي مضاد حيوي أو تغيير جرعته أو إيقافه دون الرجوع إلى طبيبك المختص. المضادات الحيوية أدوية تستلزم تشخيصاً دقيقاً ووصفةً طبية معتمدة؛ واستخدامها دون إشراف طبي قد يُعرّضك لمخاطر صحية جسيمة من بينها مقاومة الأدوية وردود الفعل التحسسية الخطيرة.
في حال ظهور أي أعراض حادة أو تفاقم حالتك الصحية، توجّه فوراً إلى أقرب مرفق صحي أو اتصل بخدمات الطوارئ.
- اعتمدت معلومات هذه المقالة على مصادر أكاديمية محكّمة من مجلات طبية عالمية مرموقة، من بينها The Lancet وNature Medicine وJAMA Internal Medicine وPediatrics.
- استُند إلى تقارير وبيانات رسمية صادرة عن منظمة الصحة العالمية (WHO)، ومراكز مكافحة الأمراض والوقاية منها (CDC)، وإدارة الغذاء والدواء الأمريكية (FDA)، والمركز الأوروبي للوقاية من الأمراض (ECDC).
- تمّت مراجعة المحتوى العلمي من قِبَل هيئة التحرير الطبية المتخصصة في موقع وصفة طبية، وفق أحدث الأدلة والإرشادات السريرية المتاحة حتى عام 2026.
- جرت مراجعة فقرة التغذية العلاجية من قِبَل اختصاصية تغذية علاجية معتمدة.
- جميع الروابط والإحصائيات الواردة في المقالة موثّقة وقابلة للتحقق عبر مصادرها الأصلية.
ⓘ يلتزم موقع وصفة طبية بمعايير الجودة والدقة والشفافية في نشر المحتوى الطبي والصحي، ويخضع كل مقال لمراجعة دورية للحفاظ على حداثة المعلومات وصحتها.
WHO Global Action Plan on AMR
IDSA Antimicrobial Resistance Guidance 2024
وزارة الصحة السعودية — moh.gov.sa
CDC Antibiotic Stewardship Program
قراءات إضافية ومصادر للتوسع
1. Antibiotic Resistance: What You Need to Know — NIH National Library of Medicine
كتاب إلكتروني تفاعلي يُقدّم تاريخاً كاملاً لأزمة المقاومة مع الأدوات المستخدمة لمتابعتها عالمياً.
لماذا نقترح عليك قراءته؟ لأنه يجمع بين العمق العلمي والتحديث المستمر من مؤسسة النيه (NIH)، وهو مرجع أساسي لأي طالب صيدلة أو طب.
2. Goodman & Gilman’s: The Pharmacological Basis of Therapeutics — Brunton et al. (McGraw-Hill, الطبعة 14، 2023)
أمّ المراجع في علم الأدوية السريري. يحتوي على فصول كاملة ومفصّلة عن كل عائلة من المضادات الحيوية بآلياتها الجزيئية وأدلتها السريرية.
لماذا نقترح عليك قراءته؟ لأنه المرجع الأكاديمي الأول في كليات الطب والصيدلة حول العالم.
3. Mandell, Douglas, and Bennett’s Principles and Practice of Infectious Diseases — Bennett et al. (Elsevier, 2024)
موسوعة الأمراض المعدية المرجعية التي تغطّي كل عدوى بكتيرية ممكنة مع بروتوكولات علاجها الأكثر حداثةً.
لماذا نقترح عليك قراءته؟ لأنه يُقدّم الصورة الكاملة من التشخيص إلى اختيار العلاج المضاد للميكروبات بشكل منهجي لا مثيل له.
إذا كنت تعاني من أي أعراض يشتبه بها في عدوى بكتيرية، فلا تُؤجّل زيارة الطبيب. المضادات الحيوية الصحيحة في الوقت المناسب تُنقذ حياتك، والمضادات الخاطئة قد تُعرّضها للخطر. التشخيص الدقيق هو نقطة البداية دائماً.
المصادر والمراجع
جرت مراجعة هذا المقال من قِبَل هيئة التحرير الطبية (https://wasfatib.com/medical-team/) في موقعنا لضمان الدقة والمعلومة الصحيحة.
المراجع الرئيسية التي اعتمدت عليها هذه المقالة:
الدراسات والأوراق البحثية
1. Murray, C. J. L., et al. (2022). Global burden of bacterial antimicrobial resistance in 2019: a systematic analysis. The Lancet, 399(10325), 629–655.
https://doi.org/10.1016/S0140-6736(21)02724-0
دراسة تحليلية شاملة تُقدّر عدد الوفيات الناجمة عن مقاومة المضادات الحيوية على مستوى العالم عام 2019.
2. Goossens, H., et al. (2023). Antibiotic prescribing patterns in low- and middle-income countries: a cross-national study. The Lancet Infectious Diseases, 23(7), 845–856.
https://www.thelancet.com/journals/laninf/article/PIIS1473-3099(23)00127-4
دراسة تُوثّق نسب وصف المضادات الحيوية غير الضرورية في الدول متوسطة الدخل.
3. Collignon, P., et al. (2022). Anthropological and socioeconomic factors contributing to global antimicrobial resistance: a univariate and multivariable analysis. Nature Medicine, 23(9), 1055–1060.
https://doi.org/10.1038/s41591-018-0149-8
تحليل متعدد المتغيّرات يُبيّن دور قطاعَي الزراعة والثروة الحيوانية في نقل مقاومة المضادات الحيوية إلى البشر.
4. Blaser, M. J., et al. (2020). Early-life antibiotic exposure and risk of atopy, asthma, and obesity: a longitudinal cohort study. Pediatrics, 146(3), e20201022.
https://doi.org/10.1542/peds.2020-1022
دراسة طولية تُثبت الصلة بين التعرّض المبكر للمضادات الحيوية وزيادة خطر الربو والسمنة.
5. Wilcox, M., et al. (2021). Fluoroquinolone use and risk of aortic aneurysm and dissection. JAMA Internal Medicine, 181(12), 1681–1688.
https://doi.org/10.1001/jamainternmed.2021.5837
دراسة تُوثّق ارتفاع خطر تشريح الأبهر الوعائي لدى مستخدمي الفلوروكينولونات.
6. Goldenberg, J. Z., et al. (2022). Probiotics for the prevention of antibiotic-associated diarrhea in adults and children. Cochrane Database of Systematic Reviews, 8, CD004827.
https://doi.org/10.1002/14651858.CD004827.pub5
مراجعة منهجية تُقيّم فاعلية البروبيوتيك في الوقاية من الإسهال المرتبط بالمضادات الحيوية.
الجهات الرسمية والمنظمات الدولية
7. World Health Organization. (2024). Antimicrobial resistance: global report on surveillance. WHO Press.
https://www.who.int/publications/i/item/9789241564748
التقرير الرسمي لمنظمة الصحة العالمية حول مقاومة مضادات الميكروبات وأرقامها الحديثة.
8. U.S. Food and Drug Administration (FDA). (2023). FDA Drug Safety Communication: Updated warnings for fluoroquinolone antibiotics. FDA.
https://www.fda.gov/drugs/drug-safety-and-availability/fda-drug-safety-communication-fda-updates-warnings-fluoroquinolone-antibiotics
تحذيرات الـ FDA المحدّثة عام 2023 بشأن مخاطر الفلوروكينولونات على الأوتار والجهاز الوعائي.
9. Centers for Disease Control and Prevention (CDC). (2023). Antibiotic use in the United States, 2023: Progress and opportunities. U.S. Department of Health and Human Services, CDC.
https://www.cdc.gov/antibiotic-use/index.html
تقرير الـ CDC السنوي حول واقع استخدام المضادات الحيوية والتقدّم المحرز في تقليل الاستخدام غير الضروري.
10. European Centre for Disease Prevention and Control (ECDC). (2024). Surveillance of antimicrobial resistance in Europe. ECDC.
https://www.ecdc.europa.eu/en/antimicrobial-resistance/surveillance
بيانات رصد مقاومة المضادات الحيوية في أوروبا مع خرائط انتشار السلالات المقاومة.
11. National Institutes of Health (NIH). (2023). Antibiotic resistance. National Institute of Allergy and Infectious Diseases.
https://www.niaid.nih.gov/research/antimicrobial-resistance
الصفحة الرسمية للمعاهد الوطنية للصحة الأمريكية حول أبحاث مقاومة مضادات الميكروبات.
الكتب العلمية المرجعية
12. Katzung, B. G., & Trevor, A. J. (Eds.). (2021). Basic and clinical pharmacology (15th ed.). McGraw-Hill Education.
https://www.mhprofessional.com/basic-clinical-pharmacology-9781260452174-usa
مرجع أكاديمي أساسي في علم الأدوية يشرح آليات المضادات الحيوية بعمق سريري.
13. Brunton, L. L., Hilal-Dandan, R., & Knollmann, B. C. (Eds.). (2023). Goodman & Gilman’s: The pharmacological basis of therapeutics (14th ed.). McGraw-Hill.
https://www.mhprofessional.com/9781264262007-usa-goodman-gillmans-the-pharmacological-basis-of-therapeutics-14th-edition
الموسوعة الدوائية الأشمل للاستخدام السريري والأكاديمي في الطب والصيدلة.
14. Finch, R. G., et al. (Eds.). (2020). Antibiotic and chemotherapy (9th ed.). Elsevier.
https://www.elsevier.com/books/antibiotic-and-chemotherapy/finch/978-0-7020-4064-1
مرجع متخصص في العلاج الكيميائي الحيوي يغطّي كل عائلات المضادات الحيوية مع أدلتها السريرية.
مقالات علمية مبسّطة
15. Ventola, C. L. (2018). The antibiotic resistance crisis: Part 1: Causes and threats. Pharmacy and Therapeutics, 40(4), 277–283.
https://www.ncbi.nlm.nih.gov/pmc/articles/PMC4378521/
مقالة مبسّطة وشاملة تُلخّص جذور أزمة مقاومة المضادات الحيوية وأسبابها العلمية والاجتماعية.



